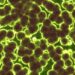

Chaque année, des milliers de touristes se rendent dans la vallée de la Bekaa, au Liban, pour photographier les majestueuses colonnes romaines de Baalbek. Ils admirent les vestiges du temple de Jupiter, immortalisent ces ruines antiques et repartent avec la conviction d’avoir été les témoins d’un nouveau triomphe de la civilisation classique. Pourtant, la grande majorité d’entre eux ignorent qu’ils viennent de marcher sur le plus grand mystère d’ingénierie de la planète : une fondation si massive et si disproportionnée que les experts modernes sont incapables d’en expliquer l’origine ou la méthode de construction.
Sous ces célèbres temples romains se cache une plateforme qui enfreint absolument toutes les règles de l’architecture antique. Les blocs de pierre qui la composent pèsent jusqu’à 1 650 tonnes. Leurs joints sont d’une précision telle qu’il est impossible d’y glisser une feuille de papier. De plus, cette structure bénéficie d’une ingénierie parasismique que les architectes modernes n’ont comprise qu’au XXe siècle. Face à ces anomalies, une question troublante s’impose : si les humains de l’Antiquité n’avaient pas besoin d’une plateforme aussi colossale, pour qui a-t-elle été construite ?

Le Trilithon : des proportions qui écrasent l’entendement
Ce que les chercheurs ont découvert dans le mur occidental du complexe ferait passer l’ingénierie romaine pour un travail d’amateur. Cette section, baptisée le Trilithon, est composée de trois blocs de pierre monumentaux. Chacun mesure environ 19 mètres de long, plus de 4 mètres de haut et près de 4 mètres de profondeur. Les estimations de leur poids varient entre 800 et 1 000 tonnes par bloc.
Pour mettre ces chiffres en perspective, il faut rappeler que les plus grosses pierres de la Grande Pyramide de Gizeh pèsent environ 80 tonnes, et que les célèbres mégalithes de Stonehenge atteignent environ 25 tonnes. Les blocs du Trilithon sont donc dix fois plus lourds que ceux des pyramides et quarante fois plus lourds que ceux de Stonehenge.
Plus impressionnant encore : ces pierres ne reposent pas à même le sol. Elles ont été soulevées à 7 mètres de hauteur et positionnées avec une précision millimétrique. Il n’y a ni mortier, ni matériau de remplissage ; c’est un assemblage direct de pierre contre pierre avec une exactitude qui met mal à l’aise les géomètres contemporains.

Le docteur Jean-Pierre Adam, un archéologue français ayant passé trois ans à documenter le site, a résumé son impression avec une grande franchise : « J’ai étudié la construction romaine toute ma carrière. Ceci n’est pas romain. Je ne sais pas ce que c’est. » De son côté, le professeur Daniel Lohmann, de l’Institut archéologique allemand, a souligné que les tolérances observées sur ces joints sont plus strictes que ce qui est réalisé aujourd’hui dans la construction de ponts modernes équipés de découpeuses au diamant et de guidage par ordinateur.
L’absence assourdissante d’archives romaines
Les Romains sont arrivés à Baalbek vers 15 avant J.-C. Ils ont rebaptisé le site Heliopolis, la « ville du soleil », et l’ont transformé en l’un de leurs complexes religieux les plus ambitieux. Le temple de Jupiter comptait autrefois 54 colonnes s’élevant à 22 mètres de hauteur. L’architecture classique y est omniprésente : chapiteaux corinthiens, frises complexes et grandeur impériale.
Cependant, la fondation sur laquelle reposent ces temples utilise une technique de construction radicalement différente et à une échelle sans commune mesure. Le paradoxe est le suivant : les Romains étaient obsédés par la documentation. Ils gravaient des inscriptions pour se vanter de chaque pont, de chaque aqueduc et de chaque monument construit. Nous savons exactement qui a commandé le Colisée et nous savons que l’empereur Hadrien a fait reconstruire le Panthéon vers 126 après J.-C.
Alors, où sont les registres détaillant le déplacement de pierres dix fois plus lourdes que tout ce qui a été fait dans l’histoire romaine ? Quel empereur s’est attribué le mérite de la plus grande prouesse technique du monde antique ? Il n’y en a aucun. C’est un silence total.
La découverte bouleversante de 2014 dans la carrière
Si le Trilithon repousse les limites du possible, la réponse à certaines questions se trouvait dans une carrière située à 800 mètres de là. En 2014, une équipe d’archéologues allemands et libanais menait des fouilles de routine lorsque leur équipement a heurté une masse anormale. Le docteur Janine Abdel Massih, qui dirigeait les fouilles, a ordonné de continuer à creuser. Les heures se sont transformées en jours, et la pierre n’en finissait pas de se dévoiler.

Lorsqu’ils ont enfin cartographié ses dimensions complètes, l’équipe est restée sans voix. Ils se trouvaient face à un bloc unique mesurant plus de 19 mètres de long et pesant environ 1 650 tonnes. Ce bloc était encore rattaché au socle rocheux, abandonné en pleine extraction, taillé avec précision et prêt pour un transport qui n’a jamais eu lieu.
Un poids de 1 650 tonnes équivaut à trois avions de ligne 747 entièrement chargés empilés les uns sur les autres, ou encore à un poids supérieur à celui de la Statue de la Liberté. C’est plus lourd que tout ce que l’humanité a documenté avoir déplacé dans toute son histoire. À proximité se trouvaient également la célèbre « pierre de la femme enceinte », un autre bloc de 1 000 tonnes, ainsi qu’un troisième bloc massif sous la découverte de 2014.
Quelqu’un a taillé ces pierres avec une précision chirurgicale, avec l’intention claire de les déplacer sur près d’un kilomètre de terrain accidenté pour les hisser à côté des autres. Puis, le chantier s’est arrêté net. Les outils ont été posés, et les constructeurs ne sont jamais revenus. Quelle catastrophe a bien pu interrompre un projet d’une telle envergure ?
Une ingénierie sismique en avance de plusieurs millénaires
Déplacer ces pierres relève de l’impossible avec les technologies documentées de l’Antiquité. Les plus grandes grues mobiles actuelles plafonnent à environ 200 tonnes dans des conditions parfaites. L’utilisation de rondins de cèdre pour faire rouler les blocs, souvent suggérée, ne tient pas : un bloc de 800 tonnes écraserait n’importe quel bois instantanément. Il faudrait remplacer les rondins en continu, avec une force de traction synchronisée de 10 000 à 40 000 travailleurs, nécessitant un système de communication dont nous n’avons aucune preuve.
Mais le plus fascinant réside dans la résistance de la structure. Le Liban est situé sur l’une des failles sismiques les plus actives de la Méditerranée. Les tremblements de terre ont ravagé la région à de multiples reprises. Les colonnes romaines se sont effondrées plusieurs fois (il n’en reste que six sur les 54 d’origine). En revanche, la fondation mégalithique n’a pas bougé d’un centimètre en plus de 2 000 ans d’activité sismique.

Des analyses par balayage laser tridimensionnel ont révélé pourquoi : les pierres s’emboîtent grâce à un système sophistiqué qui permet des micro-mouvements contrôlés pendant les séismes sans provoquer de défaillance structurelle. Les joints fléchissent légèrement, absorbent l’énergie sismique, puis reprennent leur position initiale. Les concepteurs de cette base maîtrisaient l’ingénierie parasismique à un niveau que l’humanité n’a redécouvert qu’à la fin du XXe siècle.
Des traces d’outils anachroniques et des profondeurs insoupçonnées
Le docteur Gerhard Koppler, un ingénieur allemand, a passé des mois à analyser les marques d’outils sur les pierres de fondation. Ses conclusions sont troublantes : les motifs de coupe ne correspondent pas du tout aux techniques romaines. Les Romains laissaient des marques de burin caractéristiques. À l’inverse, les mégalithes de Baalbek présentent des faces lisses suggérant des méthodes de coupe abrasives ou l’utilisation de scies à fil, des technologies que les Romains ne possédaient pas.
De plus, des relevés récents au radar à pénétration de sol ont révélé que les structures de fondation s’étendent bien plus profondément sous les pierres visibles. Il pourrait y avoir des couches entières de construction mégalithique encore enfouies, attendant d’être fouillées.

L’hypothèse qui gagne du terrain parmi certains chercheurs est fascinante : une civilisation inconnue, disposant de technologies perdues, aurait construit cette fondation (possiblement à l’âge du bronze, voire avant). Suite à un effondrement catastrophique de leur société, le chantier aurait été abandonné. Des siècles ou des millénaires plus tard, les Romains auraient découvert cette plateforme indestructible et auraient simplement bâti leurs temples par-dessus, sans jamais comprendre ni pouvoir reproduire les méthodes de construction originelles.
Cela expliquerait le silence des archives romaines, les traces d’outils anachroniques, et l’érosion beaucoup plus prononcée de la base par rapport aux ruines supérieures. Le plus grand mystère de Baalbek n’est peut-être pas de savoir comment ils ont déplacé ces pierres, mais plutôt : que cherchaient-ils à construire pour avoir besoin d’une fondation d’une telle envergure, manifestement jamais conçue pour de simples temples humains ?
Source : BlackFile